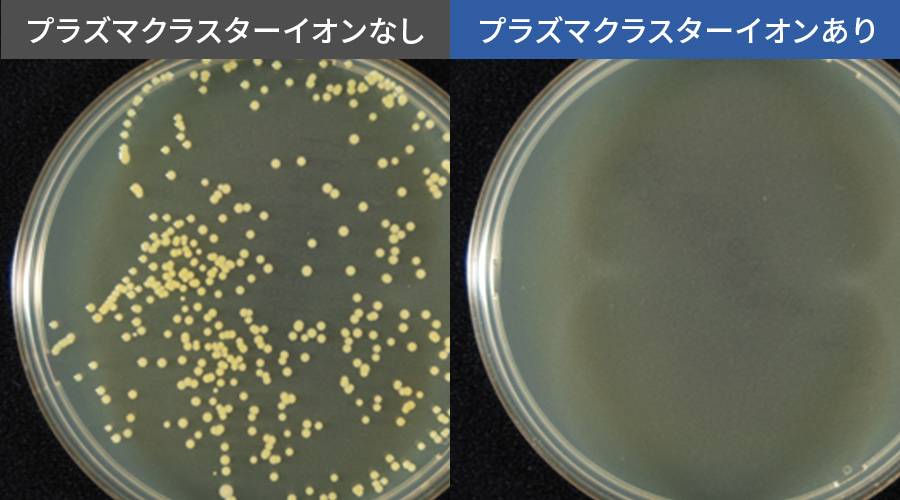

冷蔵室
きれいな冷気が冷蔵室を循環
毎日使う冷蔵室だから食品の鮮度や使いやすさはもちろん、清潔さにもこだわりたい。プラズマクラスターイオン発生ユニット搭載で、きれいな冷気が冷蔵室を循環し、清潔に保ちます。

浮遊菌を除菌※1※3
プラズマクラスターイオンが、冷蔵室内に浮遊する菌の細胞表面のタンパク質を分解、除菌します。※1※3
- ※1 浮遊菌除菌効果(1000Lのボックス内での実験結果。実使用空間での実証結果ではありません。)【試験依頼先】(一財)石川県予防医学協会【試験成績書】第14000609号【試験方法】1000Lのボックス内にプラズマクラスターイオンを放出し、その後、浮遊菌をエアーサンプラーを用いて採取し、生菌数を測定(プラズマクラスターイオン濃度:ダクト内200,000個/cm³)【試験対象】浮遊した1種類の菌【対象場所】冷蔵室内【試験結果】約73分で除去率99%以上 使用環境(庫内の食品の量・置き場所など)により、プラズマクラスターイオンの効果が異なることがあります。また、食中毒などの予防を保証するものではありません。
付着菌を除菌※2※3
プラズマクラスターイオンが冷蔵室内に放出され、庫内に付着している菌まで除菌します。※2※3
- ※2 浮遊菌除菌効果(100Lのボックス内での実験結果。実使用空間での実証結果ではありません。)【試験依頼先】(一財)石川県予防医学協会【試験成績書】第H1600196K号【試験方法】100Lのボックス内に菌を塗布した寒天培地を配置し、プラズマクラスターイオン放出6日後の生菌数を測定(プラズマクラスターイオン濃度:50,000個/cm³)【対象場所】冷蔵室内【試験結果】6日間で除去率99%以上
- ※3使用環境(庫内の食品の量・置き場所など)により、プラズマクラスターイオンの効果が異なることがあります。また、食中毒などの予防を保証するものではありません。
プラズマクラスター見守り運転
プラズマクラスターイオンの放出を自動コントロールし、庫内を清潔に保ちます。

センターピラーレス
「センターピラー*」を必要としない独自構造で、電気のムダを抑えます。(ネイチャーテクノロジーホタテ貝ドアパーツ(ホタテ貝の凹凸形状)採用。)
- *左右のドアの隙間を埋める柱。冷気もれ・霜付きを抑えるために、ヒーターを内蔵し、電力を消費します。
オートクローズ
半ドア状態(ドアと本体の距離が約10cm以内)になると、自動でドアが閉まります。
スムーズな調理を後押しする、こだわりの使いやすさ
側取り(そくどり)ポケット
ドアを全開しなくても、左右のポケットの横からサッと取り出せます。
高さ調節ドアポケット
ビンやボトルの高さに合わせて、ドアポケットの高さを調節できます。
折りたたみトレー
食品のサイズに合わせて、棚をカンタンに変えられる。高さのあるものもスッキリ収納。
棚全段取りはずし
全ての棚を取り外せるので、今まで掃除ができなかったところまで簡単にお掃除可能に。
ユーティリティルーム
チルドルーム手前の「ユーティリティルーム」は、カレールーやスパイスなどのニオイの強い食材や、迷子になりやすい小物を入れておくのに便利です。
段々スパイスポケット
チューブ類から小ビン類まで、見やすくスッキリ収納できます。ラクラク斜め配置だから、取り出しやすくて使いやすい。